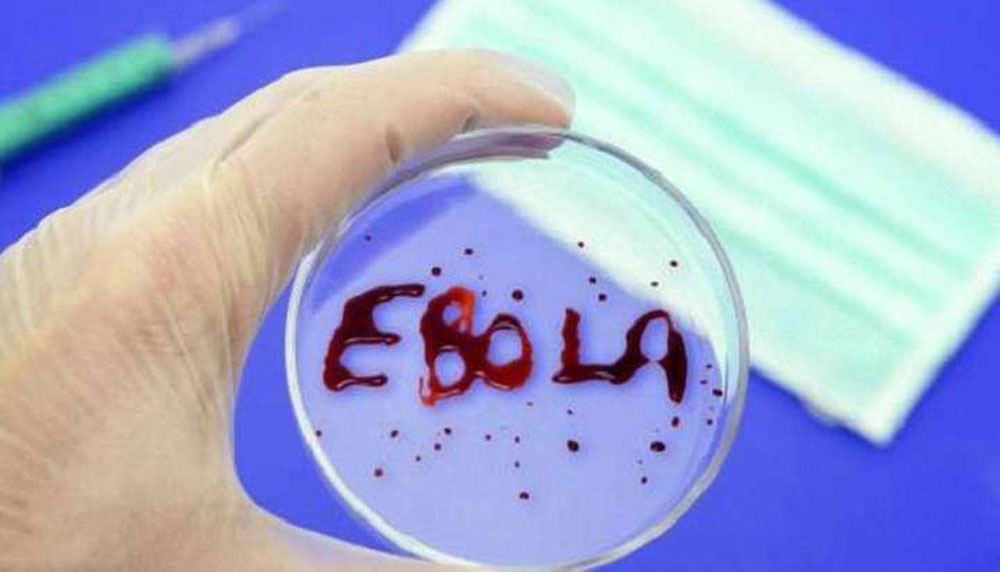
Вирус Эболы можно хранить в организме людей после месяцев выздоровления

Вирус Эболы можно хранить в организме людей после месяцев выздоровления
Исследование, проведенное учеными из Вашингтонского университета, показало, что 57,5% людей, которые выжили после вспышки Эболы в Уганде в 2022-2023 годах, сообщают о хронических и изнурительных проблемах со здоровьем, которые влияют на их повседневную жизнь.
Особая проблема была вызвана обнаружением следов вируса в организме человека, что указывает на возможность передачи вируса даже после восстановления.
«Это первое длительное исследование людей, которые пережили лихорадку Эболы в Судане, и результаты показывают, что вирус продолжает значительно влиять на их жизнь», -сказал Кариуки Нженха, глава исследования.













